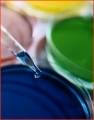
2014年1月17日 (五) 05:01的版本的缩略图

Bkjm1.jpg (180 × 230像素,文件大小:31 KB,MIME类型:image/jpeg)
单击某个日期/时间查看对应时刻的文件。
| 日期/时间 | 缩略图 | 大小 | 用户 | 备注 | |
|---|---|---|---|---|---|
| 当前 | 2014年1月17日 (五) 05:01 | | 180 × 230(31 KB) | Admin(讨论 | 贡献) |
您不可以覆盖此文件。
以下页面使用本文件:
此文件中包含有额外的信息。这些信息可能是由数码相机或扫描仪在创建或数字化过程中所添加的。如果文件自初始状态已受到修改,一些详细说明可能无法完全反映被修改的文件。
| 图像标题 |
|
|---|---|
| Exif版本 | 2.2 |
| 图像宽度 | 180 px |
| 图像高度 | 230 px |
| 水平分辨率 | 72 dpi |
| 垂直分辨率 | 72 dpi |
| 黄色和洋红配置 | 居中 |
| 数字化日期时间 | 2007年9月13日 (四) 00:34 |
| 文件修改日期时间 | 2007年9月13日 (四) 00:34 |
| 原始数据最后修改日期 | 2007年9月13日 (四) 00:34 |
| 使用软件 | Adobe Photoshop CS Windows |
| 关键词 | Business Icons 2. |
| IIM 版本 | 2 |